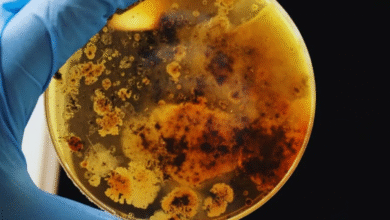
bactéria misteriosa é encontrada em estação espacial chinesa

-
Notícias

Uber inicia corridas de passageiros em trens
A Uber acaba de apresentar uma novidade que pode transformar o jeito como nos deslocamos. A empresa não está mais…
Leia mais » -
Notícias

Cientistas preveem data para próxima extinção em massa na Terra
As mudanças climáticas estão se mostrando um sério desafio para a humanidade, com previsões de que, se nada for feito,…
Leia mais » -
Notícias

Lua de sangue eclipsa luz da Terra em 08/09
Na próxima segunda-feira, dia 8, teremos um espetáculo astronômico imperdível: um eclipse lunar total, popularmente conhecido como Lua de sangue.…
Leia mais » -
Notícias

Brasil conquista Copa do Mundo de cervejas com três prêmios
As cervezas artesanais brasileiras brilharam no World Beer Cup 2025, que aconteceu em maio, em Indianápolis, nos Estados Unidos. Esse…
Leia mais » -
Notícias

azeite e bicarbonato: o que gera tanta curiosidade?
A combinação de azeite de oliva com bicarbonato de sódio tem conquistado cada vez mais espaço nas rotinas de cuidados…
Leia mais » -
Notícias

Dicas para combater o chulé e eliminar o odor desagradável
Descobrir como eliminar odores dos sapatos pode ser um verdadeiro desafio para muitos de nós, especialmente quando o famoso chulé…
Leia mais » -
Notícias

Hábito comum pode danificar sua chaleira elétrica rapidamente
Quer saber por que sua chaleira elétrica pode estar afetando o sabor do seu chá ou café? Um dos principais…
Leia mais » -
Notícias

Truque caseiro renova óculos riscados em minutos
Óculos limpos são essenciais para garantir uma visão clara e sem distrações. Hoje em dia, muitas pessoas estão em busca…
Leia mais » -
Notícias

Governo aprova medida que pode restringir recursos de brasileiros
Na última terça-feira, dia 2 de setembro de 2025, o Senado aprovou a proposta de emenda à Constituição, conhecida como…
Leia mais » -
Notícias

Bactéria desconhecida é descoberta em estação espacial da China
A descoberta de uma nova bactéria na estação espacial chinesa Tiangong está chamando atenção nas discussões sobre ciência espacial. Durante…
Leia mais »